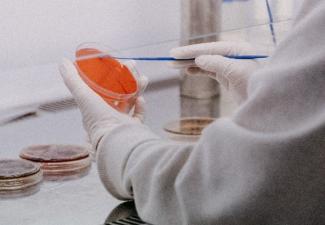
pipette

The Advancing Multifunctional Dental Biomaterials (AMDB) Research Cluster brings together experts in the fields of engineering, materials sciences, chemistry, microbiology, and dentistry. The AMDB research excellence cluster seeks to advance dental research across three main pillars: oral care, regenerative and reconstructive dental materials. The ultimate goal of the cluster is to connect disciplines and to bridge existing gaps in knowledge translation and public needs in regards to oral health.

Mission
Our goals are to build a strong and consolidated international network of researchers ; leverage dental biomaterials research nationally and internationally; engage with industry, community partners, and knowledge users; and create further opportunities for clinical translation and improvements in oral health. Additionally, we aim to utilize the cluster network as a strong platform for world-class training of highly qualified researchers in a unique, multidisciplinary, and engaging environment.
Vision
This multidisciplinary and international research excellence cluster aims to advance the field of dental biomaterials research and related fundamental sciences, facilitate the clinical translation of innovative materials, and manage highly prevalent chronic oral diseases to improve oral and general health. The close ties among researchers, academic sectors, industry, government, and knowledge users will greatly aid in the realization of this vision.

